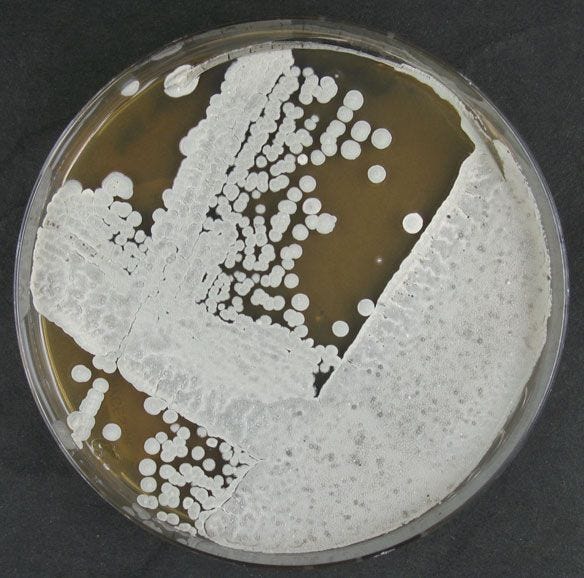
dsm 41445

Ivermectin & Population Control Poison: a Deep Dive into a Nobel Prize Winning Medicine
I know this article is going to get swarmed with hate, just like my vitamin investigations. Posting content like this leads to a loss of subscribers therefore a loss of revenue. This is why everyone will discuss how bad processed food is but few will discuss processed supplements and processed medicines. I wonder why that is? Why aren’t we allowed to ask, “What ingredients are in this? How are they made? What exactly do these ingredients do when we consume them?”… those seem like reasonable questions to me. After all, most of us read labels before buying a product at the grocery store so why is it taboo to read the label of a health product? Or a miracle cure? Is wanting to know what we are swallowing or injecting really that outrageous? I don’t think so but as I have demonstrated, simply saying, “Hey guys, this product contains hazardous ingredients. Here’s the data from the manufacturer” gets me labeled a shill, a conspiracy theorist and a confused idiot.
However, I’m not here to appease the masses and I have nothing to sell you, 100% of my income comes from donations and subscriptions, so call me whatever you’d like, cancel your account, speak ill of me, whatever you feel is justified as a response to looking at ingredients in a product famous doctors, the CDC, the NIH, Merck and Billy-boy Gates are recommending.
Over the past year, I have been obsessed with researching the foundations for what we assume to be true, yet never questioned. Alarmingly, it seems everything I have looked into is never what we have been told it is (“Vitamins”, Dinosaurs, Satellites FFS!, GeoEngineering, Covid, Covid masks, you name it, it’s probably a lie). So, when my friend Tim Truth created a video talking about Ivermectin being a fertility reducing poison pushed on us as a cure, I wasn’t surprised but I was very disappointed. The reason for my disappointment was that I never questioned what exactly Ivermectin is or what is in it. I’m not exactly sure why I blindly trusted strangers online for medical advice. I cannot come up with a single good reason, but looking back, I can clearly see the Psychological Operation (PSYOP) ran on the populous, especially with Ivermectin.
When the media came out against Ivermectin, because I don’t trust the media, I got suckered into believing it must be a wonder drug. After all, the guy who invented it won awards, right?! And so many people were saying it cured them! Not only did I blindly trust, I spent hundreds of dollars stocking up, in fear that it might be banned. I wanted to be sure this miracle treatment would be available for my family. I even saved the link to Dr. Stella Immanuel’s website where she will prescribe you Ivermectin (for a fee). (btw, it was embarrassing just to type all of that)
After listening to Tim’s show, I wanted to look into the real history of Ivermectin but there didn’t appear to be any content of this nature available online other than short-and-sweet, sugarcoated summaries on the NIH, CDC and Merck’s websites. Since I am on a mission to discover the foundation of things we assume to be true, I decided to dig into it.
Here’s my research. Hopefully you choose to read it with an open mind, and if not, that’s fine too. If Ivermectin is helping you, FANTASTIC! TAKE IT! I want everyone to do what they feel is right. I want all of us to be happy and healthy. Without further ado, let’s begin:
THE PROBLEM
Every solution starts with a problem and this is how Ivermectin came to be. You see, people living in fertile river valleys in the tropical and Sahel regions of Africa, Yemen, southern Mexico, Guatemala, Ecuador, Colombia, Venezuela, and the Brazilian Amazon were developing one, or more, of the following symptoms:
Let’s condense the list to skin and eye issues. These symptoms would eventually be named River Blindness. The medical term is Onchocerciasis.
River Blindness was such a problem that a super-creepy postage stamp would be created to raise awareness:
THE STUDIES
Nobody knew what was causing River Blindness, so in the late 1800s and early 1900s, it was suggested that perhaps black flies, which live near bodies of water, were causing the health problems (skin and eye issues).
[Keep in mind, this exact timeframe was the beginning of Virus Theory, Germ Theory, Vaccine Theory and what I will call Vitamin Theory. All of these theories are based on Immune System Theory. All of these theories rely on, “your body needs this lab-made product to be healthy”. And all of these theories are all highly profitable, that part is not a theory.]
A handful of scientific experiments were conducted to determine if black flies were the cause of these symptoms. As you read through these studies, keep in mind, this research became the foundation for what would known as Ivermectin:
A document written in 1922 discusses how eight different experiments were ran by different scientists to prove the existence of insect larvae in the bloodstream of humans who were infected with the aforementioned symptoms. All of the experiments produced, “almost completely negative results”. Meaning, nothing had been found in the blood of people deemed to be infected.
In one of those experiments, a scientist examined 2,000 cases (infected people), and only once was he able to locate larvae. In this single instance, the scientist claimed that he squeezed them out of some dudes finger (for real, that’s what the paper states). The document says, he “squeezed the finger powerfully” until it bled. That blood was used for a blood smear and, allegedly, larvae were present. Nobody was able to replicate these results. The scientist himself was unable to duplicate the result. Larvae never appeared in the remaining 1,999 infected people.
In another experiment, 290 men with skin issues were selected. Out of these 290, 24 were investigated further. Although doctors did not locate larvae inside these men they did locate tumors, lots of tumors. More studies of the same nature were conducted which also found tumors. It was then hypothesized that black flies might cause tumors.
Another set of experiments involved two men who were already suffering from the aforementioned symptoms. These men allowed black flies to bite them. The flies were then dissected. Science claimed to have discovered that the infection from the men was present in some, but not all, of the flies that bit them. Science was unable to determine the reason why half of the flies did not contain the infection.
In the three studies that followed, flies were fed something science deemed to be infected then the flies were dissected. The results were the same as the prior study, meaning some flies allegedly had the infection in them while others did not, despite consuming the same infected food.
This evidence somehow confirmed that the health problems (skin and eye issues) were likely caused by larvae. They theorized this larvae was spread from person to person through “repeated bites” of a black fly.
THE FLY BITE STUDIES
The next studies were to prove the larvae, theoretically transmitted through a fly bite, grow inside people and cause illness, which was a key component to the fly bite transmission theory. In this study, two monkeys were given injections of “advanced stage fly larvae” which the scientists claim to have extracted from the heads of dissected flies who were deemed to be carrying the infection. The scientists injected the larvae under the monkeys skin. One monkey received the injection “in the head” and the other received it “in the flank”. As of two months later, neither monkey showed any symptoms of disease. There is no further mention of the larvae.
Because the monkey studies were unsuccessful, scientists switched to using other animals and methods. These new methods involved dorsal fins, removing slices of skin then keeping the skin alive to run wacky tests on it, centrifuging blood samples to try to find larvae, and more … that was when I stopped reading because it was pointless.
After three hours of digging, I am unable to locate a single study that demonstrates a perfectly healthy person who did not have parasites, worms, larvae, nor any form of disease, was bit by a fly which transmitted larvae, causing disease. This is very concerning because it is the foundation for everything that follows. If you can find a normal study that took place on healthy humans and didn’t involve a human injecting another human with anything please share the links.
FIGHTING THE DISEASE
Up until this point, citizens who were deemed to be infected were being fed highly toxic poisons as medicine. These ineffective and deadly chemical compositions were called Diethylcarbamazine and Suramin.
Despite the medicine being labeled a cure, it was not curing anyone, so Science told the citizens that the only way they can save themselves is if they move away from the rivers to prevent the disease. The relocation had devastating impacts on the communities. When they surrendered their natural resource, the river, they were no longer near water, therefore could no easily longer grow food and now had to travel to access water. To make matters worse, the relocation did not stop the disease the flies were causing.
So, in 1974, the World Health Organization and the World Bank, along with the Food and Agriculture Organization (← the same entity who currently requires chemicals be added to our food supply under the guise of “vitamins”) and the United Nations Development Program, launched the Onchocerciasis Control Program. They ordered toxic chemicals to be repeatedly sprayed from planes directly onto the rivers to kill the flies, of course. The World Bank acted as a trust fund for this program.
Surprisingly, the repeated poisoning of the river did not stop people from developing skin and eye issues. Want to know why? Don’t you dare say, “because the flies never caused the disease to begin with”, that’s something a conspiracy theorist would say! The correct answer is, history claims, “immigrant flies began to reinvade treated rivers, and some flies developed resistance to the insecticides used by the program.” … so, to recap: feeding the people poison medicine didn’t work, moving away from the river didn’t work and poisoning the river over and over didn’t work. People were somehow still developing skin issues and eye issues.
This brings us to the discovery of Ivermectin.
A CURE IS DISCOVERED! YAY!
In 1971, a scientist named Satoshi Ōmura traveled from Japan to the US to meet with other scientists including the head of Merck Research Laboratories. He was given money by the NIH and several large pharmaceutical companies ”to search for naturally occurring novel therapeutics”. In 1973, only two years after the meeting and funding, he was contracted by Merck to work for them.
History claims, shortly after the contract was signed, Satoshi took a soil sample from a golf course and it just so happened that this sample contained a new, undiscovered bacteria. This bacteria was said to have killed parasites in soil.
Long story short, Merck created a concoction in a lab, said it was the same as the dirt-bacteria, and it was called Avermectin / Avermectin B1. Ivermectin is a chemically modified derivative of Avermectin B1.
When Ivermectin first went to market it was sold as a parasite medicine for animals. This chemical blend was labeled “25 times more potent” than existing parasite medications.
Merck’s human-drugs division realized that if Ivermectin could enter the human market the profit potential was unfathomable. So, Merck did what it needed to do to demonstrate that this product (recently discovered in that golf course soil sample then produced in a lab with chemicals) was a cure for humans too.
Since science had somehow proven River Blindness was caused by larvae transmitted through repeated bites from a black fly, this was the perfect target market for Merck’s animal product. With the support of the WHO, clinical trials began in 1981, resulting in the approval of Merck’s Ivermectin drug being used in humans. Merck named the human version of the drug Mectizan. (Mectizan was the brand name whereas Ivermectin is the generic drug name, meaning they are they same thing, both of which are derived from lab-made Avermectins, which we are told is the same as the dirt-bacteria discovered by the dude at the golf course, right after the injection of pharmaceutical company funding.)
Ivermectin would become one of Merck’s best selling products of all time. Within 25 years sales would exceeded $1 billion dollars.
Merck stated that because of the financial success of their animal parasite drug, they were able to afford to do good in the world by donating millions of doses per year to the people living in regions that have infected flies. Just in 2006, Merck donated over 69 million doses.
Now that you know the real history of Ivermectin, lets take a deeper look at what exactly it is.
HOW IT’S MADE
History claims the bacteria in the soil discovered by Satoshi Ōmura was Streptomyces avermitilis (S. avermitilis). Just like we learned in my Pfizer Cheese article and WTF! How Vitamins are Made piece, this stuff they are selling us isn’t natural. They are not bottling golf course soil bacteria. In the case of Vitamins and Ivermectin, what we are purchasing is being made in a lab through microbial fermentation. Here’s a brief overview of how Avermectins are mass produced:
S. avermitilis 41445 is the bacteria strain you start with:
yeast extract malt extract glucose (YMG) is fed to the bacteria to grow it:
ethidium bromide (EB) is needed
ethyl methanesulfonate (EMS) is needed
ultraviolet (UV) radiation is used to grow the bacteria
Other optional ingredients:
All of those ingredients are going to eventually result in the production of Avermectins, which they call industrially derived mutants. But get this…
IVERMECTIN: DEADLY INSECTICIDE
These lab-made GMO Avermectins, created from mutant bacteria (Streptomyces avrrmitillis) are so toxic that they kill Arthropods.
Arthropods are invertebrates with jointed legs, including lobsters, crabs, scorpions, bees, butterflies, spiders and more.
They make up about 84% of all animals on Earth.
Arthropods have a major role in maintaining ecosystems as pollinators, recyclers of nutrients, scavengers and food for other animals. But if you want to kill them, Ivermectin works great! Need to massacre some blue crabs? Get out the Ivermectin:
Yep, Ivermectin is an excellent poison to slaughter these dudes:
One must ask, how much of the 84% OF ALL CREATURES IN THE WORLD can this substance kill?
Because of its effectiveness in demolishing Arthropods, Avermectin B1 / Abamectin / Ivermectin is used as an insecticide.
And only 0.05% of it is needed to kill life:
It is the main active ingredient in cockroach killer:
Ivermectin was registered as Fire Ant Killer with the EPA back in the 1980s and has been used as an ant killer ever since.
And to kill the alleged parasites in our bloodstream (transmitted from fly bites), this poison has to be in our blood. I know people are going to say, “It’s only toxic to insects! It doesn’t hurt people!“. I find it really strange how often people say this now. Vitamin D IS Rat Poison, but they tell me it doesn’t hurt people. Vitamin B3 IS insecticide that contaminated a city, but that doesn’t hurt people either. K2 IS pesticide and rat poison, but it doesn’t hurt people. Vitamin B is made from cyanide, but it’s a special type of cyanide that doesn’t hurt people (also developed by Merck). Ivermectin IS insecticide, but it doesn’t hurt people. Why are all these vitamins and miracle cures literal poison that kills life? And what do all of these healthy poisons have in common? Merck, Bill Gates, the United Nations and pals give them away for free to help people… Does nobody else find that fact to be eyebrow-raising?…
And I know someone is going to say, “Everything is poison! It’s the dose that makes it safe!” - NO, everything is not poison. Nobody got diabetes from eating too many apples. Nobody had a heart attack from too much broccoli. Hell, nobody has ever become obese from pounding bags of carrots all day. Not everything is poison. And nobody ever died from drinking too much clean water either. I might write a post just on that because it is the most common rebuttal and it’s simply false.
For the sake of being a thorough journalist, just to be 100% sure this product is only poison for 84% of life on earth but not humans, let’s check out the manufacturers safety data sheets for Ivermectin:
THE SAFETY DATA SHEETS
A Manufacturers Safety Data Sheet (MSDS / SDS) is what is provided by the company who makes the chemical product. The MSDS outlines how to handle the product, how to dispose of it without damaging the environment, what to do if it is inhaled or swallowed, if employees need to wear respirators around it, health issues that result from the product, etc. You can’t get any closer to the truth than by looking at the data directly from the company who makes the product because, for legal reasons, the manufacturer cannot lie or sugarcoat Safety Data Sheets.
Here’s Merck’s Safety Data Sheet (MSDS) for Veterinary Ivermectin, meaning what will be given to animals:
In Section 2 of the MSDS we see this is a very toxic product. Category 1 means it can inflict permanent damage with a single exposure. Category 2 means it can inflict damage with repeated or prolonged exposure. We also learn that it attacks the Central Nervous System:
An attack on the Central Nervous System (CNS) can result in a wide range of horrible side effects including vision loss / blindness, infections (such as meningitis, carpal tunnel syndrome), paralysis, severe headaches, confusion, seizures, weakness, Guillain-Barré Syndrome, stroke, and genetic predisposition. But that’s not all. A CNS attack can also result in a plethora of skin issues including Skin Discoloration (Ataxia-telangiectasia and Tuberous sclerosis complex). This is Tuberous sclerosis complex, a side effect of a Central Nervous System attack:
This is River Blindness, caused by larvae:
Tuberous sclerosis complex rash, a side effect of a Central Nervous System attack:
River Blindness caused by larvae:
In Section 3 of the Veterinary MSDS for Ivermectin we are provided with a list of chemicals in the product:
I don’t want to dive into all of these, but here’s a couple:
Propylene Glycol (“PG”) removes water, therefore it is dumped into everything to act as a preservative. It is also used as a flavoring agent, a dough-strengthener and an emulsifier. You will find this chemical in pharmaceuticals, foods, and personal care products. As with all chemicals, it too is toxic and this product specifically causes kidney injury.
Interestingly, PG can also cause “sepsis-like syndrome”. According to the WHO, spesis is caused by bacteria or parasites.
So, 49% of each dose of animal Ivermectin can cause the identical problems it is taken to stop or prevent. But no need to worry, that’s Ivermectin made for animals, not people. The FDA has classified PG as generally safe for humans to eat:
Butanone is another ingredient in animal Ivermectin. It is also used in plastic welding because it dissolves plastic. It is used in dry erase markers to make the erasable dye… and it is great for healthy medicines for animals and humans.
Butanone accounts for 10% of the animal product and it too is hugely toxic. In fact, it is so toxic that as of 2010, the United States Environmental Protection Agency (EPA) was forced to add butanone to its dangerous, toxic chemicals list because of the neuropsychological effects it causes due to being rapidly absorbed through undamaged skin and lungs. This dangerous chemical also contributes to the formation of ground-level ozone, which is toxic, even in low concentrations. But people are going to say, “This is for animals, not humans!”. Ok, let’s make sure that is true…
Next we will look at Fisher’s MSDS for Ivermectin. This Safety Data Sheet specifies to only use it in a lab and not to use it a “food, drug, pesticide” or to kill anything.
The reason I show you this is because, even though this Ivermectin states not to use it as food, medicine or pesticide, it has the exact same hazard classifications at the veterinary use Ivermectin:
Additionally, you will see that this product is labeled hazardous. It also damages fertility and can harm an unborn baby. In fact, it is a Category 1A, which means “known human reproductive toxicant” (meaning, it is not suspected to cause harm, it does cause harm):
In the image above, we also see that it is Fatal if Swallowed.
Here we see that if it is ingested a poison center should be called immediately. We also learn it is “very toxic to aquatic life”.
I know the response is going to be, “But that says not to use as medicine! Show me a safety data sheet for the medicine version or you're a shill!” - Ok, I will do you one better than that.
I went on a mission to find the best of the best of the absolute best, most-purest-ever Ivermectin. I was able to locate a couple USP grade Ivermectin’s that exceed pharmaceutical standards. These are as pure and clean as it is ever going to get!
Here it is, at the hefty price of $144 for only one kilo (2 pounds)!
Let’s check out Spectrum Chemicals MSDS for Ivermectin, USP grade (purest of purest of pure!). This one even says to use it as a medication (for humans)!
As we can see from the image above, this Ivermectin is a mixture of two Avermectins.
The good news is, although this product is considered Hazardous, it is a Category 2 and 3 Hazard. This means it might cause permanent damage with repeated or prolonged use and it is suspected of causing harm but it is not guaranteed that it will cause harm, so that’s good.
If we scroll down to Label Elements we see the same warnings as the other products:
And the skull graphic is required, because it is deadly.
To be more specific the skull pictogram means Acute Toxicity. The legal definition is, “Acute toxicity means that exposure to a single dose of the chemical may be toxic or fatal if inhaled or swallowed, or if it comes into contact with the skin.”
Oh look, it also can affect the central nervous system, just like the other Ivermectins:
When this product ships it must ship as Toxic Solids and Hazardous Waste:
In Europe, three additional Hazard Classes must be added in addition to a second skull:
To recap: the animal version of Ivermectin is a hazardous toxin, the lab-use-only version is a hazardous toxin and even if you spend the money to buy the absolute best, top shelf, cleanest-ever Ivermectin, it is still a hazardous poison that is “very toxic if swallowed”.
MERCK, THE EPA AND THE GOVERNMENT
Remember how, on the purest-of-pure Ivermectin USP grade MSDS, it says Ivermectin is a mixture of Avermectins (mutant bacteria stuff made in a lab):
I located a 2008 document from the Canadian Government website, OEHHA.ca.gov. In the document they discuss the US government labeling Avermectin B1 a reproductive toxin back in 1994.
Because Merck was making Ivermectin using Avermectin, this same document features a response from Merck regarding the safety of Ivermectin. Quote:
“Merck states that primates are less sensitive to the acute effects of abamectin and its analog, ivermectin, than rodents. The commenter implies that because humans are primates, abamectin should be less toxic in humans than in rodents.” … “Abamectin interferes with gamma-aminobutyric acid (GABA) transmission and, as such, produces neurotoxic clinical signs such as tremors, ataxia, convulsions, or coma that are more severe in rodents and dogs than primates.”… ”There are no developmental studies with abamectin in primates. Therefore, EPA believes that the rodent studies cited in the proposed rule provide sufficient evidence that abamectin can reasonably be anticipated to cause developmental toxicity in humans.” - well that’s interesting, eh?
IVERMECTIN AND FERTILITY REDUCTION
Tim did a deep dive into Ivermectin and how it plummets fertility. While you listen to this, remember that everything is based on the premise that a black fly transmits larvae that causes skin issues and blindess. (58 minute video. If it won’t play, audio-only version is below. If that won’t play either, watch on Bitchute).
Audio Version:
He also made a follow-up video called The Deadly Toll of Ivermectin: Blindness, Comas & Deaths Induced By The Neurotoxic, Genotoxic Poison.
You can also follow Tim on:
Rokfin: https://rokfin.com/timtruth
Odysee: https://odysee.com/@TimTruth:b/
Rumble: https://rumble.com/timtruth
Bitchute: https://bitchute.com/timtruth/
And of course, follow him on Substack!:
Tim and my buddy dpl did a fantastic podcast on Ivermectin:
In closing I will say this:
I was not able to find evidence that black flies transmit larvae which causes disease. Last year I wrote a pretty fantastic multi-part series about Rockefeller desperately trying to prove mosquitoes transmit Yellow Fever Virus. He was unsuccessful so the trials were rigged. The black fly situation is eerily similar to mosquitoes.
I have seen the little graphic floating around the internet that says all diseases, including cancer, is caused by parasites. This means, you are a healthy person, parasites somehow get inside you and they give you cancer, meaning, everyone with cancer has parasites and if you did not have parasites you would be cancer-free. - I cannot find any evidence of this. I will write a deep dive into this topic because I did find a lot of other really interesting things through researching. For example, parasites show up in sharks to save them. Yes, you read that correctly. Without the help of the parasites the shark would die from toxic heavy metals!
What I am saying is, assuming parasites really are inside of people, are parasites a cause or a symptom? The parasites in the shark did not cause heavy metal toxicity. The toxic heavy metals the shark is living in are the cause. The parasites are a symptom of the cause. If not for the polluted water, would the shark have parasites?
If we were to feed the shark insecticide to kill the parasites, would this help the shark? It doesn’t seem like it. The shark would still be living in dirty water and now it would have consumed poison, thus killing the creatures inside of it that were eating the poison. Now the shark has dead creatures, full of poison inside of it, to go along with the poison it consumed to kill the creatures. Meanwhile, the shark is still living in contaminated water.
If the entire premise is, we are eating poison (Ivermectin) so the poison gets into our bloodstream where it acts as an insecticide and kills the parasites in our blood, why is this being promoted as a cure for “Covid Virus”? If insecticide is the cure for “Covid”, then we have to say Covid is caused by insects, right? Do you truly believe that? Do you sincerely believe parasites somehow got inside everyone all over the world and made us sick for a couple weeks? If Covid is not caused by insects (arthropods), then why are we consuming insecticide for it? I have already shared my theory of what Covid actually was, and it sure wasn’t little critters in our bloodstreams.
I wonder what the interactions between Ivermectin and “vitamins” are. They are all assorted poison and genetically modified organisms. What happens when you combine food that has been fortified with Vitamin A (an extreme population control agent) and Vitamin D (rat poison) with orally dosed Vitamin C (mold, another GMO bacteria, GMO sugar, chemicals, linked to The Royal Society) and orally dosed Omega-3’s (primarily Soy, which is another fertility reducing agent hence the reason Billy-boy Gates loves it). What is the interaction between all of these GMOs and chemicals? I don’t know. Nobody knows because it has never been studied and it never will be. And what if we are eating this stuff with Pfizer Cheese, which is what 90% of the cheese in the USA is now?
IF IT’S HELPING YOU, GREAT, TAKE IT! If you need more, pay Doctor Stella Immanuel, or any of the famous doctors, to write you a script for the insecticide.
If you appreciate me (and Tim ) throwing ourselves on the sword financially to bring you this information, please consider supporting us. It really helps offset the unsubscribes and hate mail.
NEXT READ:
SOURCES, NOTES AND OTHER STUFF:
Some of the early research papers efforts to prove fly bites and larvae:
https://www.ncbi.nlm.nih.gov/pmc/articles/PMC2453973/?page=3
https://dn720006.ca.archive.org/0/items/biostor-274972/biostor-274972.pdf
Here’s a whole bunch more stuff I didn’t use in the article but I like to leave it in here for anyone who wants to continue learning:
HOW “HORSE PASTE” IVERMECTIN IS MADE
As you will see, it is all a bunch of chemicals, ranging from dangerous to deadly. Whether it’s a paste, a pill or an injection, it’s going to be a variation of all of the same poisons.
A Gelling Agent: carboxyvinyl polymers (Carbomers), cellulose derivatives, polysaccharide gums, homo- and copolymers of acrylamide, of alkyl acrylate, of acrylic acid, and/or of 2-acrylamido-2-methylpropane sulfonic acid (AMPS), clays and native or GMO starches
A Polyol
A Chelating agent
A pH adjusting agent
An Oil Agent: vegetable, mineral, animal and/or synthetic oils, such as alkyl esters, silicone oils, paraffin oils and mixtures thereof.
Thickening Agent: Stearyl and/or cetyl alcohol, linear fatty acids, vegetable waxes, silicone gums and mixtures thereof.
Preservative: alkyl parahydroxybenzoate (paraben), phenoxyethanol and mixtures thereof
Antioxidant and an Emulsifier: sorbitan ester, a polyoxyethylene ether of fatty alcohol, a polyoxyethylene fatty acid ester, a glyceryl ester; and mixtures thereof.
Avermectin - This is what we discussed making earlier. You will need to add that to this.
Glycol: (C1-C6) alkylene glycols and poly(C1-C6) alkylene glycols, such as ethylene glycol, propylene glycol, polyethylene glycol, polypropylene glycol, butylene glycol, pentylene glycol and hexylene glycol and their mixtures.
Alcohol: ethanol, isopropanol and butanol, oleyl alcohol or Guerbet alcohols
This is all going to be mixed together, heated and cooled, until it is complete.
There are 137 Current Manufacturers of Ivermectin https://www.pipelinepharma.com/ivermectin-manufacturers
https://web.archive.org/web/20200806214937/https://www.gmpplus.org/en/publications/gmp-news/2017-11-30-newsletter-ba1-en-faq-en/
https://www.merck.com/product/usa/pi_circulars/s/stromectol/stromectol_pi.pdf
MERKS IVERMECTIN “STROMECTOL”
INGREDIENTS:
"is available in 3-mg tablets containing the following inactive ingredients: microcrystalline cellulose, pregelatinized starch, magnesium stearate, butylated hydroxyanisole, and citric acid powder (anhydrous)."
MERCKS SAFETY DATA SHEET INCLUDES TESTING INFO https://www.merck.com/product/usa/pi_circulars/s/stromectol/stromectol_pi.pdf
https://www.merck.com/product/usa/pi_circulars/s/stromectol/stromectol_pi.pdf
https://pubchem.ncbi.nlm.nih.gov/compound/Ivermectin
https://www.sciencedirect.com/topics/agricultural-and-biological-sciences/streptomyces-avermitilis
https://www.britannica.com/science/Streptomyces
https://www.sciencedirect.com/topics/agricultural-and-biological-sciences/streptomyces-avermitilis
https://en.wikipedia.org/wiki/Ivermectin
https://tecoland.com/ivermectin/
https://www.avma.org/javma-news/2021-01-01/drugmaker-accused-unsafe-manufacturing
https://en.wikipedia.org/wiki/Ivermectin
https://www.drugs.com/compare/ivermectin-vs-permethrin-topical
https://japan-forward.com/amazing-science-the-soil-sample-from-an-izu-golf-course-that-changed-the-world/
https://www.acs.org/education/whatischemistry/landmarks/ivermectin-mectizan.html
https://web.archive.org/web/20210730213401/https://citeseerx.ist.psu.edu/viewdoc/download?doi=10.1.1.823.6887&rep=rep1&type=pdf
“, there was a significant difference (p<0.05) between the hyaluronidase activities of serum and semen in sheep. After the injection of ivermectin subcutanously at a dose of 0.2 mg/kg, the values of sperm concentration were demonstrated to decrease highly significantly (p<0.001) in comparison with the control group” https://dn790007.ca.archive.org/0/items/10.1.1.595.9853/10.1.1.595.9853.pdf
MSDS
https://www.fishersci.com/store/msds?partNumber=AAJ6277703&productDescription=IVERMECTIN+1G&vendorId=VN00024248&countryCode=US&en
https://www.merck.com/docs/product/safety-data-sheets/ah-sds/Ivermectin
https://www.riverblindness.eu/onchocerciasis/life-cycle/l1-l2-l3-in-the-vector/
Looking for 71827-03-7 / Ivermectin API manufacturers, exporters & distributors?
https://web.archive.org/web/20210730213401/https://citeseerx.ist.psu.edu/viewdoc/download?doi=10.1.1.823.6887&rep=rep1&type=pdf
https://en.wikipedia.org/wiki/Onchocerciasis#History
https://www.ncbi.nlm.nih.gov/pmc/articles/PMC2453973/
Pub Chem https://pubchem.ncbi.nlm.nih.gov/compound/Ivermectin#section=CAS
In very specific regions of the world there are these special flies that suck up this tainted blood, worms and all. The microscopic worms hiding in the blood are so tiny that tons of them fit up the flies microscopic sucker-tube. The worms somehow bypass the flies stomach by migrating to the flies head and it’s mouth (sucker), where they wait patiently for the right time to strike:
When the fly bites another person and the worms come rushing out through the flies sucker. Once inside the human, the worms will grow and grow and grow, for nine to 11 years or more, until they look like spaghetti:

I feel so stupid... I used 'horse paste' for "parasites" per information in a parasite group I was in...
Fast forward a few years to recent times. During COVID I had stopped my HIV meds because of other information I came across about HIV and Viruses not existing... Between these two things, I ended up with NO T-CELLS, and ended up in the hospital for Cryptococcal Meningitis. So did my Cryptococcal Meningitis come from the Ivermectin? I feel now, I'm lucky to be alive... not 100% yet. I really am having trouble knowing what the truth is for health. If HIV is "not a virus" or the cause of me loosing the T-Cells, then WHAT is? My best thinking got me in the hospital with Cryptococcal Meningitis. So I back peddled and just let the allopathic doctors do their thing. Just a few pills. By the time I figure out the truth about me and health, my life will be over! I appreciate your information Mr. Agent.
It has been a heartbreaking experience for me, and others I suspect, to realize that COVID was a mass trauma inducing psyop, and the ultra nefarious endgame of all the cabal narratives and attacks.
Now, thanks to reading some of your material, I have to contend with the psychological impact of some other cherished beliefs, regarding supplements and IVM, come crashing down.
Fortunately for me I’m just after the truth, and I respect anyone sincerely trying to get there. I’m aware that no one knows everything. Once I got past the covid con, seeing 9/11 as a psyop was easy once a key thing happened: Dubya called the J6ers domestic terrorists. Then my eyes were opened to the overwhelming evidence, which I rejected before, that things were not at all as claimed. And, 9-11 fits in perfectly with the agenda.
I saw and liked some of TimTruth’s analysis of the COVID jab contents, and of the E Palestine train debacle. I was not receptive to his IVM coverage initially. Some people claim temporary relief from jab injuries (Fred Pye comes to mind) from IVM, and successful treatment of respiratory troubles (“Covid”). However you bring the receipts from the manufacturers safety sheet. I still wonder if small doses of these poisons could have therapeutic benefits, but I prefer taking nothing from Pharma companies.
I don’t believe Dr. Merritt or Dr. Yoho, both of whom have sounded the alarm about all sorts of problems with institutional medicine and the Covid tyranny, are ill intentioned. It is tough to re-examine one’s cherished beliefs constantly, basically being in a situation where you know little conclusively.